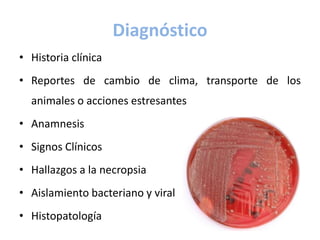
Diagnóstico
• Historia clínica
• Reportes de cambio de clima, transporte de los
animales o acciones estresantes
• Anamnesis
• Signos Clínicos
• Hallazgos a la necropsia
• Aislamiento bacteriano y viral
• Histopatología

Pasteurella es un género de bacterias Gram negativas que causan pasteurelosis neumónica, también conocida como fiebre de embarque. Esta enfermedad respiratoria aguda afecta principalmente al ganado joven y es multifactorial, causada por la interacción de virus como IBR y bacterias como P. haemolytica, facilitada por el estrés del transporte. Los signos clínicos incluyen fiebre, depresión y dificultad respiratoria. El diagnóstico se basa en la historia clínica, signos